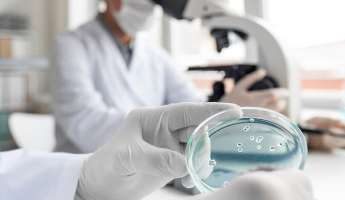
Generic Histology

OBJECTIVES
To acquire knowledge and develop skills as under

Knowledge
-
Comprehend the normal disposition, clinically relevant interrelationship, Functional and cross sectional anatomy of the various structures in the body.
-
Identify the microscopic structure and correlate elementary infrastructures of Various organs and tissues and correlate the structures with the functions as a prerequisite for understanding the altered state in various disease process.
-
Comprehend the basic structure and connection of the central nervous system To analyse the integrative functions of the organ and system. He/She shall be able to locate the site of gross lesions according to the deficits encountered.
-
Demonstrate the knowledge of the basic principles and sequential development of the organs and systems, recognize the critical stages of development and effects of common teratogens, genetic mutations and environmental hazards. He/She shall be able to examine the developmental basis of the major variations and abnormalities.

Goal : To inculcate rational and scientific basis of therapeutics

Skills
-
Identify and locate all the structures of the body and mark the topography of the living anatomy.
-
Identify the organs and tissues under the microscope.
-
Understand the principles of karyotyping and identify the gross congenital abnormalities.
-
Understand the principles of newer imaging techniques and interpretation of Computerised tomography (CT) scan, sonogram etc.
-
Understand clinical basis of some common clinical procedures. i.e. intramuscular and intravenous injection, lumbar puncture, kidney biopsy etc
INTEGRATION : horizontal and vertical integration with different subjects